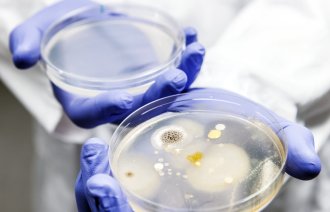
Bildet viser petridisker med bakterievekster.

Svk, pvk og arteriekateter: Har laget nasjonal veileder

– Det er viktig å hindre at intravaskulære katetre blir inngangsport for infeksjoner, sier Nina Kristine Sorknes i Folkehelseinstituttet.
Sammen med Regionalt kompetansesenter for smittevern i Helse Vest, har Folkehelseinstituttet (FHI) laget en nasjonal veileder for å forebygge infeksjoner knyttet til bruk av intravaskulære katetre.
Veilederen tar for seg perifert venekateter (pvk), sentralt venekateter (svk) og arterielt perifert kateter, også kalt arteriekateter. Alle kan være inngangsport for infeksjoner i blodbanen.
Komplisert å lage
– Dette er en av de mest alvorlige typene infeksjon man kan få, og har høy dødelighet, sier Nina Kristine Sorknes, intensivsykepleier og seniorrådgiver i FHI.
– Derfor er det viktig å hindre at slike katetre blir inngangsport for infeksjoner.
Å ha rutiner for å forebygge kateterassosierte infeksjoner er noe helsevesenet er pålagt.
– Men i stedet for at hvert enkelt sykehus lager sine egne prosedyrer, har vi sammen med de regionale kompetansesentrene, utarbeidet en nasjonal veileder med den best tilgjengelige kunnskapen, sier Sorknes.
– Så er det opp til sykehusene å ta den i bruk.
Veilederen inneholder graderte anbefalinger til praksis og viser hvilke prosedyrer man har fulgt for å komme frem til hvert enkelt råd.
Ifølge Nina Kristine Sorknes har det vært et komplisert arbeid.
Ulike graderinger
Det bekrefter Anne Dalheim, hygienesykepleier i Helse Bergen. Hun har ledet arbeidsgruppen som har jobbet frem veilederen, og ført den i pennen sammen med Sissel Frostad Oftedal.
I arbeidet har de blant annet gått gjennom internasjonale retningslinjer og systematiske oversikter og vurdert dem ut fra metodikk og anvendbarhet.
– Underveis var det noen uavklarte spørsmål, og vi oppdaget blant annet at en anbefaling kunne være gradert høyt i én retningslinje, og lavt i en annen, forteller hun.
Til slutt valgte arbeidsgruppen ut fire retningslinjer, som de la til grunn for den norske veilederen.
– Vi visste fra start at alle sykehus har egne prosedyrer, sier hun.
– Derfor måtte vi være veldig klar på kunnskapsgrunnlaget.
Nina Kristine Sorknes sier det ikke nødvendigvis er sånn at det er feil i lokale prosedyrer.
– Men hver enkelt avdeling har ikke ressurser til å gjøre litteratursøk og finne den best tilgjengelige kunnskapen. Den jobben kan vi gjøre.
Anne Dalheim sier det kan skape usikkerhet når ting gjøres på ulike måter, sykehus imellom og også innad i samme sykehus.
– Det fører også til at pasienter behandles litt ulikt, sier hun.
I Helse Bergen er det å lage felles prosedyrer et ledd i et pågående prosjekt om bedre dokumentstyring.
Dalheims erfaring er at ansatte er fornøyd med felles, kunnskapsbaserte prosedyrer og at det oppleves trygt å bruke dem.
Erstatter innsatsområde
Det er særlig sentrale venekatetre (svk) som er assosiert med blodbaneinfeksjoner. Det finnes ikke eksakte tall på hvor mange blodbaneinfeksjoner i Norge som kan knyttes til svk, men over halvparten av pasientene på norske intensivavdelinger har et slikt kateter.
– Slike katetre legges inn på de mest alvorlig syke pasientene, og det krever god etterlevelse av anbefalinger for innleggelse og stell for å hindre at ikke kateteret blir en inngangsport for infeksjon, sier Sorknes.
Pasientsikkerhetsprogrammet hadde tidligere det å forebygge infeksjoner ved svk som en egen tiltakspakke. Dette er nå omdefinert til et innsatsområde som Pasientsikkerhetsprogrammet og FHI samarbeider om.
Anbefaler tiltakspakker
I veilederen anbefales avdelingene å etablere infeksjonsforebyggende tiltakspakker. Ifølge Nina Sorknes viser forskning at slike pakker, eller care bundles, er mer effektivt enn enkelttiltak. Pakkene kan tilpasses lokale forhold, men bør inkludere grunnleggende tiltak.
– Noen ting er det ikke mulig å lage lokale variasjoner på. Aseptikk, for eksempel, er ikke et begrep som kan tolkes, sier hun.
Dette er helt grunnleggende tiltak som alle må følge:
- Benytt aseptisk teknikk ved all håndtering av intravaskulære katetre
- Utfør håndhygiene umiddelbart før ren eller aseptisk oppgave ved all håndtering av intravaskulære katetre
- Bruk ulike huddesinfeksjonsmidler før innleggelse av intravaskulære katetre etter alder og kontraindikasjoner
- Daglig vurdering av indikasjon og infeksjonsrisiko. Det er en nær sammenheng mellom katetertrombose og infeksjon
- Skylling av intravaskulære katetre gjennomføres før, mellom og etter infusjoner
- Alle kraner eller porter representerer potensielle inngangsporter for mikroorganismer inn til det intravaskulære systemet
Vil gjerne ha innspill
Veilederen har konkrete anbefalinger for pvk, svk og arteriekateter. Anne Dalheim sier de også kunne hatt med picc-line og midline, og håper veilederen etter hvert kan utvides med disse.
Nina Sorknes håper helsepersonell ser at de overordnede infeksjonsforebyggende prinsippene kan overføres til disse katetrene, og også andre, uten at de er nevnt spesifikt.
– Jeg håper det er en forståelse der ute for at de grunnleggende tiltakene skal gjennomføres, uavhengig av katetertype, sier hun.
Hun sier det har vært bred enighet om anbefalingene i arbeidsgruppen, men at veilederen på grunn av pandemien ikke er sendt ut på en bred høring.
– Vi tenker likevel den står seg godt, sier hun.
– Men vi tar gjerne imot innspill. Veilederen vil revideres løpende.
Les veilederen her: Veileder for forebygging av infeksjoner ved bruk av intravaskulære katetre

0 Kommentarer